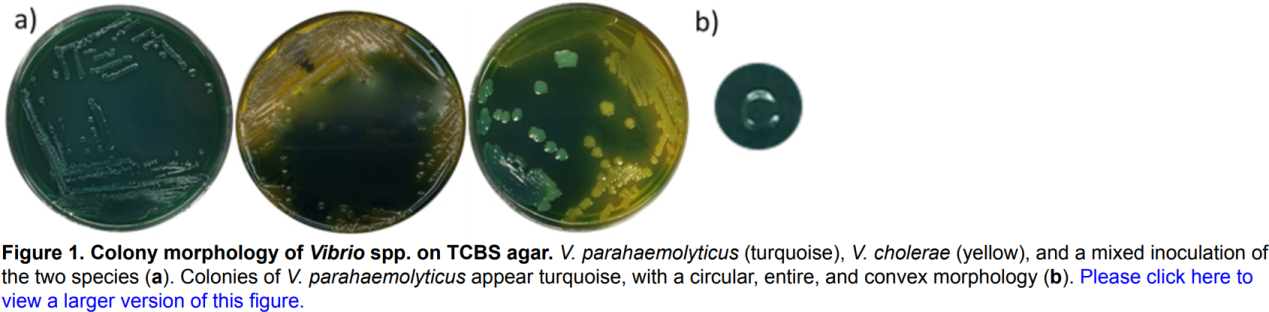
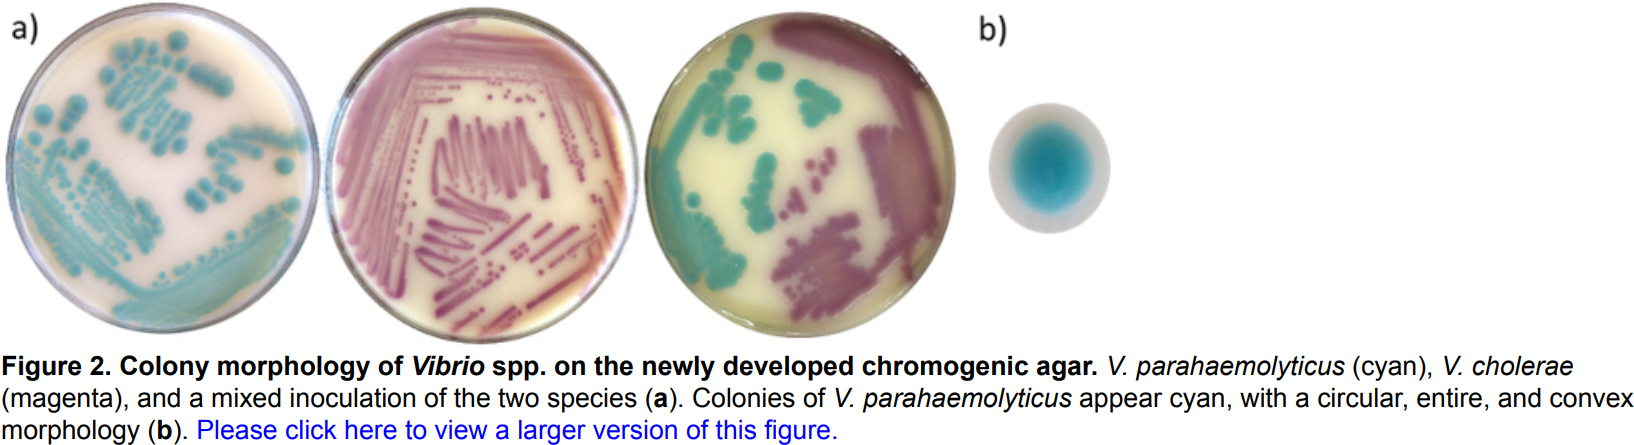

用于检测副溶血性弧菌和其他弧菌的灵敏和特异性显色培养基的研制
发布时间:2024-09-06 浏览次数:1037
大多数副溶血性弧菌菌株对人类无致病性,但致病性亚型已引起流行病和大流行,因此该物种在许多国家被认为是重要的食源性病原体。在弧菌属中,副溶血性弧菌是大多数弧菌相关感染的原因。因此,准确区分弧菌和检测副溶血性弧菌对确保食品供应安全至关重要。尽管分子技术越来越普遍,但依赖培养的方法仍然是常规的,在某些情况下,它们被视为标准方法。
通常,TCBS培养基是用于分离和检测副溶血性弧菌、霍乱弧菌和创伤弧菌的选择性和差异培养基。然而,据报道,该培养基存在局限性,例如无法将霍乱弧菌与其他弧菌物种区分开来。此外,蔗糖和pH指示剂是TCBS的分化,正发酵反应伴随着pH指示剂溴百里酚蓝的颜色变化,但培养基的着色是TCBS的缺点,因为它可能会模糊对菌落形态的观察。因此,需要开发具有更好灵敏度和特异性的替代培养基,用于检测和分离副溶血弧菌和其他近亲菌种。
该研究测试了一种新配制的显色琼脂培养基,目的是提供一种更好的分离和区分临床相关弧菌的方法。这项研究评估了新显色培养基检测和分离霍乱弧菌、副溶血弧菌和创伤弧菌的能力,特别是其将副溶血性弧菌与其他物种区分开来的能力。并比较了新显色培养基和常规培养基检测副溶血性弧菌的灵敏度、特异性和检测限。
在这项研究中,共54个微生物菌株,其中包括副溶血弧菌属22个菌株、19个其他弧菌属和13个非弧菌属(表1)。

进行了四项单独的试验,以确定菌株在TCBS上的生长和菌落形态(图1)。
测试了一种新的显色培养基从食品和环境样品中选择临床相关弧菌物种的能力。此外,评估了该培养基同时区分这些物种的能力(图2)。如表1所示,TCBS和显色琼脂对非弧菌微生物都表现出一定程度的选择性。
按照过夜培养的标准平板计数法,在接受最高稀释因子(即df=10-8)的显色琼脂平板上观察到副溶血性弧菌的菌落。这些结果与非选择性培养基(TSAS)上的结果相当。表明显色培养基的检测限与非选择性培养基相似,在没有食物基质的情况下约为10个细胞或更低。与非选择性培养基相比,其他弧菌物种如溶藻弧菌、河弧菌和少女弧菌的检测能力也不错。然而,一些霍乱弧菌、创伤弧菌和拟态弧菌菌株在显色琼脂上产生的菌落减少了10至100倍。在显色或其他选择性培养基中使用的选择性试剂不可避免地抑制某些细胞。例如,受损的细胞在选择性培养基中无法恢复。尽管如此,在大多数采用浓缩步骤的常规程序中,检测能力稍差并不是问题。食品或环境样品中的少量微生物会在浓缩液中大量繁殖,超过检测限。通常在碱性蛋白胨水中进行富集,以确定环境样品中弧菌种类的流行率。
在存在牡蛎匀浆的情况下,显色琼脂继续显示出良好的回收率。换句话说,很大比例(>70%)的副溶血性弧菌细胞能够在生色琼脂上生长,不受牡蛎基质的影响(图3a)。副溶血性弧菌细胞的生长和恢复也不受另一种弧菌的影响(图3b)。这是一个重要的属性,因为环境样品必然含有不同的弧菌种类,特别是在富集程序之后,这些种类的数量很高。

为了进一步比较显色琼脂和TCBS琼脂,计算了敏感性和特异性。表2显示了这些培养基准确识别副溶血性弧菌的能力。敏感性与真阳性率有关,这意味着副溶血性弧菌菌株在培养基上产生了预期的菌落形态。特异性与真阴性的百分比有关,这意味着非副溶血性弧菌菌株应表现出较差或无生长,或与副溶血弧菌不同的菌落形态。TCBS对副溶血性弧菌的敏感性和特异性分别为86.4%和71.8%。相比之下,显色培养基的敏感性和特异性分别为90.9%和96.9%。

使用显色培养基的优点是周围培养基的着色最小,从而有助于分离特定菌落。新开发的显色培养基利用高pH值和高盐度来抑制许多海洋样品中发现的非弧菌物种的生长。新的显色培养基的最终pH值为8.6±0.2。每升去离子水含有10克蛋白胨、10克海盐混合物、10克牛胆、10克硫代硫酸钠、5克酵母提取物、5克柠檬酸钠、2.2克碳酸钠、2克乳糖、0.5克丙酮酸钠、0.3克显色混合物和15克琼脂。显色混合物允许弧菌根据其产生某些酶的不同能力进行分化。不同的弧菌在新的显色培养基上表现出不同的菌落颜色,而不是改变TCBS琼脂培养基的颜色。
显色培养基在副溶血性弧菌的鉴定中表现出比TCBS更好的性能,其敏感性和特异性分别为90.9%和96.9%,高于TCBS(分别为86.4%和71.9%)。除此以外,该研究中使用的显色琼脂还可以区分比TCBS更多的弧菌种类,因为培养基配方中包含显色混合物,产生多种颜色。总之,新的显色琼脂是检测副溶血性弧菌并将其与其他弧菌区分开来的有效培养基。
来源:微生物安全与健康网。
